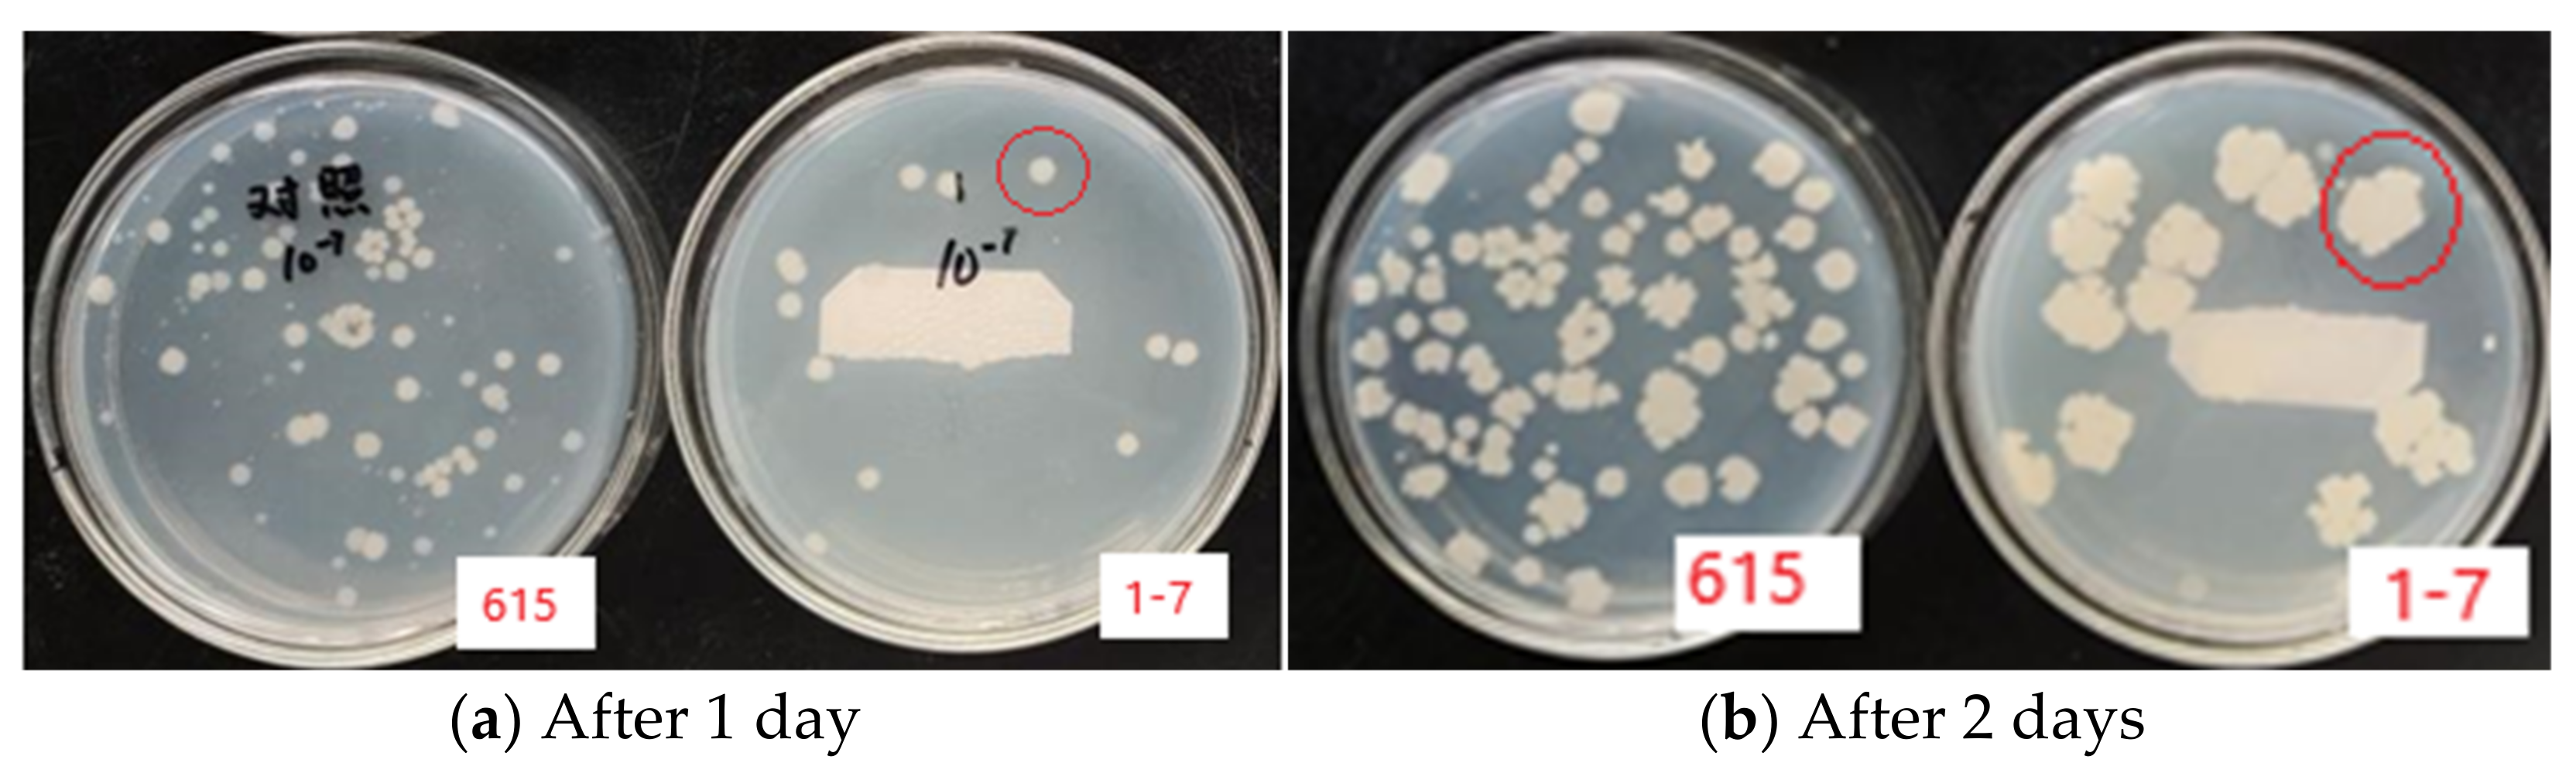
Agronomy 12 00166 g005 550

Mutation of Bacillus velezensis Using Corona Discharge
Abstract
:1. Introduction
2. Materials and Methods
2.1. Bacillus velezensis Strains and Media
2.2. Corona Discharge Treatment
2.3. Corona Discharge Current and Lethality Rate
2.4. Enzyme Activity Analysis
3. Results
4. Discussion
5. Conclusions
Author Contributions
Funding
Data Availability Statement
Conflicts of Interest
References
- Hlordzi, V.; Kuebutornye, F.K.; Afriyie, G.; Abarike, E.D.; Lu, Y.; Chi, S.; Anokyewaa, M.A. The use of Bacillus species in maintenance of water quality in aquaculture: A review. Aquac. Rep. 2020, 12, 100503. [Google Scholar] [CrossRef]
 - Farias, T.C.; Kawaguti, H.Y.; Koblitz, M.G.B. Microbial amylolytic enzymes in foods: Technological importance of the Bacillus genus. Biocatal. Agric. Biotechnol. 2021, 8, 102054. [Google Scholar] [CrossRef]
 - Gutiérrez-Chávez, C.; Benaud, N.; Ferrari, B.C. The ecological roles of microbial lipopeptides: Where are we going? Comput. Struct. Biotechnol. J. 2021, 19, 1400–1413. [Google Scholar] [CrossRef] [PubMed]
 - Lalloo, R.; Maharajh, D.; Görgens, J.; Gardiner, N. A downstream process for production of a viable and stable Bacillus cereus aquaculture biological agent. Appl. Microbiol. Biotechnol. 2010, 86, 499–508. [Google Scholar] [CrossRef] [PubMed] [Green Version]
 - Banat, I.M.; Makkar, R.S.; Cameotra, S.S. Potential commercial applications of microbial surfactants. Appl. Microbiol. Biotechnol. 2000, 53, 495–508. [Google Scholar] [CrossRef] [PubMed]
 - Tanakaran, Y.; Matra, K. The Influence of Atmospheric Non-thermal Plasma on Jasmine Rice Seed Enhancements. J. Plant Growth Regul. 2021, 1–10. [Google Scholar] [CrossRef]
 - Rasooli, Z.; Barzin, G.; Mahabadi, T.D.; Entezari, M. Stimulating effects of cold plasma seed priming on germination and seedling growth of cumin plant. S. Afr. J. Bot. 2021, 142, 106–113. [Google Scholar] [CrossRef]
 - Pérez-Pizá, M.C.; Prevosto, L.; Grijalba, P.E.; Zilli, C.G.; Cejas, E.; Mancinelli, B.; Balestrasse, K.B. Improvement of growth and yield of soybean plants through the application of non-thermal plasmas to seeds with different health status. Heliyon 2019, 55, e01495. [Google Scholar] [CrossRef] [PubMed] [Green Version]
 - Li, K.; Zhong, C.; Shi, Q.; Bi, H.; Gong, B. Cold plasma seed treatment improves chilling resistance of tomato plants through hydrogen peroxide and abscisic acid signaling pathway. Free Radic. Biol. Med. 2021, 172, 286–297. [Google Scholar] [CrossRef] [PubMed]
 - Wang, T.; Wu, Y.; Li, Z.; Sha, X. Potential impact of active substances in non-thermal discharge plasma process on microbial community structures and enzymatic activities in uncontaminated soil—ScienceDirect. J. Hazard. Mater. 2020, 393, 122489. [Google Scholar] [CrossRef] [PubMed]
 - Ono, R.; Uchida, S.; Hayashi, N.; Kosaka, R.; Soeda, Y. Inactivation of bacteria on plant seed surface by low-pressure RF plasma using a vibrating stirring device. Vacuum 2016, 136, 214–220. [Google Scholar] [CrossRef]
 - Belov, A.; Vasilyev, A.; Musenko, A. Application of high-voltage discharges for disinfection and activation of irrigation water. Irrig. Drain. 2020, 70, 185–194. [Google Scholar] [CrossRef]
 - Takaki, K.; Yoshida, K.; Saito, T.; Kusaka, T.; Yamaguchi, R.; Takahashi, K.; Sakamoto, Y. Effect of electrical stimulation on fruit body formation in cultivating mushrooms. Microorganisms 2014, 2, 58–72. [Google Scholar] [CrossRef] [PubMed] [Green Version]
 - Takaki, K.; Yamazaki, N.; Mukaigawa, S.; Fujiwara, T.; Kofujita, H.; Takahasi, K.; Narimatsu, M.; Nagane, K. Effect of pulsed high-voltage stimulation on Pholiota nameko mushroom yield. Acta Phys. Pol. A 2009, 115, 1062–1065. [Google Scholar] [CrossRef]
 - Renita, A.A.; Vardhan, K.H.; Kumar, P.S.; Ngueagni, P.T.; Abilarasu, A.; Nath, S.; Kumari, P.; Saravanan, R. Effective removal of malachite green dye from aqueous solution in hybrid system utilizing agricultural waste as particle electrodes. Chemosphere 2021, 273, 129634. [Google Scholar] [CrossRef] [PubMed]
 - Kuwahara, T.; Kuroki, T.; Yoshida, K.; Saeki, N.; Okubo, M. Development of sterilization device using air nonthermal plasma jet induced by atmospheric pressure corona discharge. Thin Solid Films 2012, 523, 2–5. [Google Scholar] [CrossRef]
 - Singh, S.; Dhillon, A.; Goyal, A. Enhanced catalytic efficiency of Bacillus amyloliquefaciens SS35 endoglucanase by ultraviolet directed evolution and mutation analysis. Renew. Energy 2020, 151, 1124–1133. [Google Scholar] [CrossRef]
 - Jiangsu Bureau of quality and technical supervision of the People’s Republic of China. Determination of Feed Bacillus in Feed. DB32/T 2583-2013. 2013. Available online: https://www.renrendoc.com/paper/89078336.html (accessed on 4 January 2022).
 - Standardization Administration of the People’s Republic of China, SAC. Food Additive-Alpha-Amylase Preparation. GB 8275-2009. 2009. Available online: https://www.antpedia.com/standard/5868134-1.html (accessed on 4 January 2022).
 - Ma, C.; Nikiforov, A.; De Geyter, N.; Morent, R.; Ostrikov, K.K. Plasma for biomedical decontamination: From plasma-engineered to plasma-active antimicrobial surfaces. Curr. Opin. Chem. Eng. 2022, 36, 100764. [Google Scholar] [CrossRef]
 - Zhang, Y.; Liu, L.J.; Ouyang, J.T. On the negative corona and ionic wind over water electrode surface. J. Electrost. 2014, 72, 76–81. [Google Scholar] [CrossRef]

| Number | Sample | Voltage | Time | Current | Number of Viable Bacteria | Lethality Rate | 
|---|---|---|---|---|---|---|
| 1 | None | 5 kV | / | 48 μA | / | / | 
| 2 | None | 10 kV | / | 118 μA | / | / | 
| 3 | None | 12 kV | / | 201 μA | / | / | 
| 4 | Powder | 5 kV | 5 min | 55 μA | (7.00 ± 2.67) × 108 | −23.5% | 
| 5 | Powder | 10 kV | 30 min | 121 μA | (5.33 ± 0.89) × 108 | 5.99% | 
| 6 | Powder | 15 kV | 15 min | 199 μA | (4.93 ± 0.78) × 108 | 13.1% | 
| Control | Powder | / | / | / | (5.67 ± 0.50) × 108 | / | 
| 7 | Liquid | 5 kV | 30 min | 50 μA | (2.67 ± 0.44) × 108 | 38.3% | 
| 8 | Liquid | 10 kV | 15 min | 137 μA | (2.33 ± 0.16) × 108 | 46.2% | 
| 9 | Liquid | 15 kV | 5 min | 231 μA | (1.93 ± 0.24) × 108 | 55.4% | 
| Control | Liquid | / | / | / | (4.33 ± 0.45) × 108 | / | 
| 10 | Medium | 5 kV | 15 min | 46 μA | (1.50 ± 0.47) × 108 | 76.1% | 
| 11 | Medium | 10 kV | 5 min | 118 μA | (1.80 ± 0.60) × 108 | 71.3% | 
| 12 | Medium | 15 kV | 30 min | 204 μA | (0.57 ± 0.16) × 108 | 91.0% | 
| Control | Medium | / | / | / | (6.27 ± 0.25) × 108 | / | 
| Sample | Voltage | Time | |||
|---|---|---|---|---|---|
| K (Powder) | 17.26 | K (5 kv) | 11.17 | K (5 min) | 10.73 | 
| K (Liquid) | 6.93 | K (10 kv) | 9.46 | K (15 min) | 8.76 | 
| K (Medium) | 3.87 | K (15 kv) | 7.43 | K (30 min) | 8.57 | 
| K’ (Powder) | 5.75 | K’ (5 kv) | 3.72 | K’ (5 min) | 3.57 | 
| K’ (Liquid) | 2.31 | K’ (10 kv) | 3.15 | K’ (15 min) | 2.92 | 
| K’ (Medium) | 1.29 | K’ (15 kv) | 2.47 | K’ (30 min) | 2.85 | 
| R (Sample) | 4.46 | R (Voltage) | 1.24 | R (Time) | 0.72 | 
| Strain | Initial value | NB1 | NB2 | SM3 | 
|---|---|---|---|---|
| 615 | 1.0 × 107 | 5.7 × 108 | 2.5 × 108 | 1.1 × 108 | 
| 1-7 | 1.0 × 107 | 7.6 × 109 | 1.0 × 109 | 4.5 × 108 | 
Publisher’s Note: MDPI stays neutral with regard to jurisdictional claims in published maps and institutional affiliations.  | 
© 2022 by the authors. Licensee MDPI, Basel, Switzerland. This article is an open access article distributed under the terms and conditions of the Creative Commons Attribution (CC BY) license (https://creativecommons.org/licenses/by/4.0/).
Share and Cite
Wang, R.; Bian, W.; Hu, Z.; Wang, L.; Yuan, C.; Takahashi, K.; Takaki, K. Mutation of Bacillus velezensis Using Corona Discharge. Agronomy 2022, 12, 166. https://doi.org/10.3390/agronomy12010166
Wang R, Bian W, Hu Z, Wang L, Yuan C, Takahashi K, Takaki K. Mutation of Bacillus velezensis Using Corona Discharge. Agronomy. 2022; 12(1):166. https://doi.org/10.3390/agronomy12010166
Chicago/Turabian StyleWang, Ranran, Wei Bian, Zhuran Hu, Lirong Wang, Chunhong Yuan, Katsuyuki Takahashi, and Koichi Takaki. 2022. "Mutation of Bacillus velezensis Using Corona Discharge" Agronomy 12, no. 1: 166. https://doi.org/10.3390/agronomy12010166
APA StyleWang, R., Bian, W., Hu, Z., Wang, L., Yuan, C., Takahashi, K., & Takaki, K. (2022). Mutation of Bacillus velezensis Using Corona Discharge. Agronomy, 12(1), 166. https://doi.org/10.3390/agronomy12010166
        
                                                
